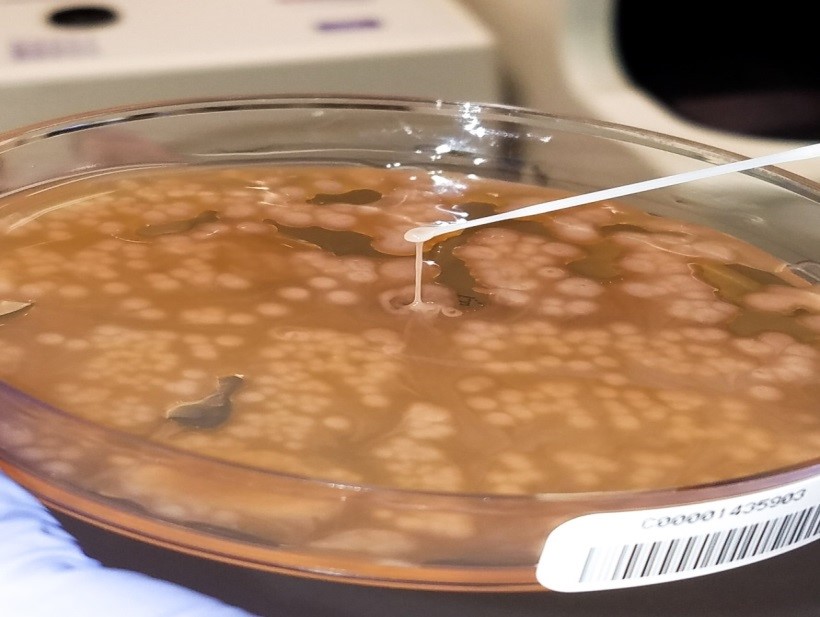
kleb3

Case history
A middle-aged male presented to the hospital emergency room with the complaints of malaise, shaking and chills for the last two days. He denied any runny nose, cough, abdominal pain, nausea, vomiting, headache or known sick contacts. His past medical history was significant for alcohol use disorder. Imaging of the abdomen revealed an ill-defined region of decreased attenuation in the right lobe of the liver measuring 4.8 x 4.7 x 2.2 cm. The Gram stain of the abscess showed 4+ WBCs (PMNs) and 4+ gram negative rods with a very large capsule surrounding them (Image 1). The organisms grew very mucoid colonies on 5% sheep blood, chocolate, and MacConkey agars (Image 2). A string test performed on the mucoid bacterial colonies was >5 mm (Image 3).

Discussion
The organism was identified as Klebsiella pneumoniae by MALDI-TOF MS. Based on the mucoid capsule and positive string test, this organism was further identified as hypermucoviscous K. pneumoniae.
Hypermucoviscous K. pneumoniae is a relatively newly recognized hypervirulent variant of K. pneumoniae. It was first described in the Asian Pacific rim and is now increasingly recognized in Western countries. Defining clinical features include serious, life-threatening community-acquired infection in younger healthy hosts, an unusual feature for enteric gram negative bacilli in the non-immunocompromised population. It can cause a variety of diseases including, but not limited to liver abscess, pneumonia, meningitis, osteomyelitis, necrotizing fasciitis and endophthalmitis.
Intestinal colonization, appears to be a critical step leading to infection. It is seen mostly in Asians, raising the issue of a genetic predisposition vs. geospecific strain acquisition. The increased virulence might be due to the ability to more efficiently acquire iron and perhaps an increase in capsule production, which confers the hypermucoviscous phenotype to the organism. The vehicles for acquisition and subsequent colonization appear to be food and water, person-to-person transmission (e.g., close contacts such as family members or sexual partners) or animal-to-person transmission (e.g., between pets and their owners).
To date, most strains of hypermucoviscous K. pneumoniae have been very susceptible to antimicrobials except ampicillin. However, in recent literature, propensity for hypermucoviscous Klebsiella pneumoniae to become multi-, extreme or pandrug-resistant, including the acquisition of extended-spectrum β-lactamases (ESBL) and carbapenemases has been reported. Since hypermucoviscous K. pneumoniae strains often cause abscesses, source control is a major aspect of the overall management plan and a need to drain abscesses and closed space infections is essential for optimal outcome.
References
- Alyssa S. Shon, Rajinder P.S. Bajwa and Thomas A. Russo; Hypervirulent (hypermucoviscous) Klebsiella pneumonia: A new and dangerous breed; Virulence 4:2, 107–118; February 15, 2013; 2013 Landes Bioscience
- Bonnie C Prokesch, Michael TeKippe, Jiwoong Kim, Prithvi Raj, Erin McElvania TeKippe, David E Greenberg; Primary osteomyelitis caused by hypervirulent Klebsiella pneumonia; The Lancet Infectious Diseases , Volume 16 , Issue 9 , e190 – e195

-Muhammad Ahmad, MD is a 2nd year anatomic and clinical pathology resident at University of Chicago (NorthShore) program based at Evanston Hospital, Evanston, IL. His academic interests include breast pathology and cytopathology.

-Erin McElvania, PhD, D(ABMM), is the Director of Clinical Microbiology NorthShore University Health System in Evanston, Illinois.